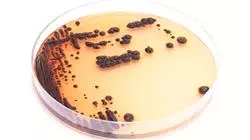

Universitäre Qualifikation
Die größte Fakultät für Krankenpflege der Welt"
Präsentation
Dank dieses 100%igen Online-Programms beherrschen Sie die fortschrittlichsten Diagnosemethoden, um das Vorhandensein von multiresistenten gramnegativen Bakterien zu bestätigen“

Im Gesundheitswesen stellen Infektionen, die durch multiresistente gramnegative Bakterien verursacht werden, eine wachsende Herausforderung für die Gesundheitsfachkräfte dar. Einer der Hauptgründe dafür ist, dass die Resistenz gegen antimikrobielle Mittel die Behandlung von häufigen Infektionen im klinischen Umfeld erschwert. In dieser Hinsicht spielen Pflegekräfte eine wichtige Rolle bei der Umsetzung von Maßnahmen zur Infektionskontrolle, um dieses globale Phänomen zu bekämpfen. Dazu müssen diese Experten die modernsten Strategien in ihre Routinepraxis einbeziehen, um die Wirksamkeit von Antibiotikabehandlungen zu gewährleisten und damit die Lebensqualität ihrer Patienten zu optimieren.
Vor diesem Hintergrund führt TECH ein umfassendes und innovatives Programm in Multiresistente Gramnegative Bakterien für die Krankenpflege ein. Der Studiengang wurde von Spezialisten auf diesem Gebiet konzipiert und wird eine umfassende Analyse der Epidemiologie dieser Mikroorganismen beinhalten. Dies ermöglicht es den Fachkräften, das Vorhandensein solcher Bakterien bei den Nutzern in einem frühen Stadium zu erkennen. Der Lehrplan vermittelt auch die Grundlagen für eine ganzheitliche klinische Beurteilung von Patienten mit Infektionsverdacht. Ebenso werden im Rahmen des Programms verschiedene Antibiotikabehandlungen zur Bekämpfung dieser Bakterien untersucht, um das Wohlergehen der Menschen zu gewährleisten.
Es ist erwähnenswert, dass TECH für die Durchführung dieses Programms eine vollständige Bildungsumgebung entwickelt hat, die auf die Bedürfnisse von Berufstätigen mit vollen Terminkalendern zugeschnitten ist. Auf diese Weise können diese Experten ihre Zeitpläne und Bewertungen individuell verwalten. Der Unterricht beinhaltet auch die revolutionäre Relearning-Methode, die auf der Wiederholung von Schlüsselkonzepten basiert, um das Wissen optimal zu festigen. Das Einzige, was Fachkräfte benötigen, ist ein elektronisches Gerät mit Internetzugang, um auf den virtuellen Campus zuzugreifen. Auf diese Weise erhalten sie das vollständigste und aktuellste Unterrichtsmaterial auf dem akademischen Markt, um einen Qualitätssprung in ihrer beruflichen Laufbahn als Pflegekräfte zu machen.
Sie erhalten Zugang zu einem spezialisierten Universitätsprogramm, das auf Ihren Beruf abgestimmt ist, um die Behandlung von Patienten mit multiresistenten gramnegativen Bakterien täglich zu verbessern“
Dieser Universitätskurs in Multiresistente Gramnegative Bakterien für die Krankenpflege enthält das vollständigste und aktuellste wissenschaftliche Programm auf dem Markt. Die wichtigsten Merkmale sind:
- Entwicklung von Fallstudien, die von Experten für Mikrobiologie, Medizin und Parasitologie vorgestellt werden
- Der anschauliche, schematische und äußerst praxisnahe Inhalt vermittelt alle für die berufliche Praxis unverzichtbaren wissenschaftlichen und praktischen Informationen
- Die praktischen Übungen, bei denen der Selbstbewertungsprozess zur Verbesserung des Lernens durchgeführt werden kann
- Sein besonderer Schwerpunkt liegt auf innovativen Methoden
- Theoretische Lektionen, Fragen an den Experten, Diskussionsforen zu kontroversen Themen und individuelle Reflexionsarbeit
- Die Verfügbarkeit des Zugangs zu Inhalten von jedem festen oder tragbaren Gerät mit Internetanschluss
Sie werden Ihr Verständnis für die klinischen Akteure beim Erwerb von Infektionen vertiefen und sowohl zur epidemiologischen Überwachung als auch zur Kontrolle von Ausbrüchen beitragen“
Der Lehrkörper des Programms besteht aus Fachkräften des Sektors, die ihre Berufserfahrung in diese Fortbildung einbringen, sowie aus anerkannten Spezialisten von führenden Gesellschaften und renommierten Universitäten.
Die multimedialen Inhalte, die mit der neuesten Bildungstechnologie entwickelt wurden, werden der Fachkraft ein situiertes und kontextbezogenes Lernen ermöglichen, d. h. eine simulierte Umgebung, die eine immersive Fortbildung bietet, die auf die Ausführung von realen Situationen ausgerichtet ist.
Das Konzept dieses Programms konzentriert sich auf problemorientiertes Lernen, bei dem die Fachkraft versuchen muss, die verschiedenen Situationen aus der beruflichen Praxis zu lösen, die während des gesamten Studiengangs gestellt werden. Zu diesem Zweck wird sie von einem innovativen interaktiven Videosystem unterstützt, das von renommierten Experten entwickelt wurde.
Möchten Sie die modernsten Instrumente zur Einschätzung des Risikos multiresistenter gramnegativer Mikroorganismen effektiv nutzen? Erreichen Sie das mit diesem Programm"

Durch die revolutionäre Relearning-Methode von TECH integrieren Sie das gesamte Wissen auf optimale Weise, um einen Qualitätssprung in Ihrer Karriere als Pflegekraft zu erleben"
Lehrplan
Dieses Programm vermittelt den Pflegekräften ein umfassendes Verständnis der Entwicklung und Verbreitung von multiresistenten gramnegativen Bakterien. Der Lehrplan befasst sich sowohl mit der Epidemiologie dieser Infektionen als auch mit der Pathogenese. Auf diese Weise werden die Pflegekräfte wirksame Kontrollmaßnahmen durchführen, um die Ausbreitung der Krankheit in den Gesundheitseinrichtungen zu verhindern. Der Lehrplan vermittelt auch die Grundlagen für eine umfassende klinische Beurteilung von Patienten, die von dieser Pathologie betroffen sind. In diesem Zusammenhang wird das Programm auf die Bedeutung ergänzender Untersuchungen wie Bluttests oder bildgebende Untersuchungen hinweisen.
Sie können die Symptome von Infektionen erkennen, die durch multiresistente gramnegative Bakterien verursacht werden, und Präventivmaßnahmen zur Verringerung der Übertragung dieser Bakterien anwenden“
Modul 1. Multiresistente gramnegative Bakterien
1.1. Infektionen durch gramnegative Mikroorganismen
1.1.1. Epidemiologie von gramnegativen Mikroorganismen
1.1.2. Gemeinschafts- und nosokomiale Infektionen durch gramnegative Mikroorganismen
1.1.3. Relevanz von Infektionen mit multiresistenten gramnegativen Mikroorganismen
1.2. Pathogenese von Infektionen mit gramnegativen Mikroorganismen
1.2.1. Faktoren im Zusammenhang mit gramnegativen Mikroorganismen
1.2.2. Patientenfaktoren bei gramnegativen Infektionen
1.2.3. Andere Faktoren bei gramnegativen Infektionen
1.3. Klinische Beurteilung von Patienten mit multiresistenten gramnegativen Infektionen
1.3.1. Anamnese
1.3.2. Klinische Beurteilung der Patienten
1.3.3. Andere Informationen von Interesse
1.4. Ergänzende Tests bei multiresistenten gramnegativen Infektionen
1.4.1. Blutuntersuchungen
1.4.2. Bildgebende Tests
1.4.3. Mikrobiologische Techniken
1.5. Einschätzung des Schweregrads bei Patienten mit multiresistenten gramnegativen Infektionen
1.5.1. Traditioneller Ansatz zur Einschätzung des Schweregrads
1.5.2. Neue Instrumente zur Einschätzung des Schweregrads
1.5.3. Praktische Schlussfolgerungen
1.6. Risiko des Erwerbs von Infektionen mit multiresistenten gramnegativen Mikroorganismen
1.6.1. Klinische Faktoren beim Erwerb von multiresistenten gramnegativen Infektionen
1.6.2. Weitere Faktoren für den Erwerb multiresistenter gramnegativer Infektionen
1.6.3. Instrumente zur Abschätzung des Risikos des Auftretens multiresistenter gramnegativer Mikroorganismen
1.7. Empirische Behandlung bei Verdacht auf multiresistente gramnegative Infektionen
1.7.1. Beteiligte Mikroorganismen je nach Standort
1.7.2. Umfassende Beurteilung von Patienten mit Verdacht auf multiresistente gramnegative Infektionen
1.7.3. Auswahl einer empirischen Antibiotikabehandlung
1.8. Gezielte Therapie bei multiresistenten gramnegativen Infektionen
1.8.1. Anpassung der Antibiotikatherapie entsprechend den mikrobiologischen Ergebnissen
1.8.2. Nachsorge von multiresistenten gramnegativen Infektionen
1.8.3. Wichtigste Nebenwirkungen einer Antibiotikatherapie
1.9. Dauer der Antibiotikatherapie bei multiresistenten gramnegativen Infektionen
1.9.1. Schätzung der Dauer der Antibiotikabehandlung bei multiresistenten gramnegativen Infektionen
1.9.2. Relevanz der Fokuskontrolle bei multiresistenten gramnegativen Infektionen
1.9.3. Besondere Überlegungen zur Antibiotikatherapie bei diesen Infektionen
1.10. PROA-Teams bei multiresistenten gramnegativen Infektionen
1.10.1. PROA-Teams: Geschichte
1.10.2. Auswirkungen der PROA-Teams auf die korrekte Anwendung von Antibiotika-Behandlungen
1.10.3. Herausforderung für PROA-Teams bei der Behandlung multiresistenter gramnegativer Infektionen

Ein flexibles Universitätsprogramm, ohne feste Termine und mit Inhalten, die 24 Stunden am Tag verfügbar sind. Schreiben Sie sich jetzt ein!”
Universitätskurs in Multiresistente Gramnegative Bakterien für die Krankenpflege
Der von der TECH Technologischen Universität angebotene Universitätskurs in Multiresistente Gramnegative Bakterien für die Krankenpflege das Wissen und die Fähigkeiten vermitteln, die für einen wirksamen Umgang mit Infektionen durch gramnegative Erreger wie „Pseudomonas aeruginosa“, „Acinetobacter baumannii“ oder „Escherichia coli“ erforderlich sind. Diese Bakterien stellen eine wachsende Bedrohung für das Gesundheitswesen dar, da sie in der Lage sind, Resistenzen gegen mehrere Antibiotika zu entwickeln, was ihre Behandlung und Kontrolle erschwert. Unser Institut zeichnet sich durch sein Engagement für eine hochwertige Ausbildung aus und bietet Online-Unterricht an, der den Studenten einen flexiblen und bequemen Zugang zu den Kursinhalten ermöglicht. Dieses Format ist ideal für Pflegefachkräfte, die ihre Karriere vorantreiben wollen, ohne ihre beruflichen und persönlichen Verpflichtungen zu beeinträchtigen. Online-Unterricht bietet einen einfachen Zugang zu hochmodernen Lehrmaterialien und ermöglicht es den Teilnehmern, in ihrem eigenen Tempo und von überall aus zu lernen.
Studieren Sie multiresistente gramnegative Bakterien online
Der Kursinhalt deckt ein breites Spektrum an Themen ab, die für die Behandlung von multiresistenten gramnegativen bakteriellen Infektionen wichtig sind. Die Studenten erforschen die Mechanismen der bakteriellen Resistenz, Diagnose- und Behandlungsstrategien sowie bewährte Verfahren zur Infektionsprävention und -kontrolle im klinischen Umfeld. Darüber hinaus wird besonderer Wert auf den umsichtigen Einsatz von Antibiotika und die Umsetzung von Infektionskontrollprotokollen gelegt, die die Verbreitung dieser resistenten Bakterien minimieren. Die Lehrmethode ist zu 100% online und kombiniert interaktive Studienmaterialien, Videovorträge, Fallstudien und Diskussionsforen. Die Studenten haben die Möglichkeit, von Experten auf diesem Gebiet zu lernen und praktische Fähigkeiten zu entwickeln, die sie direkt in ihrem Arbeitsumfeld anwenden können. Schreiben Sie sich jetzt für den Universitätskurs in Multiresistente Gramnegative Bakterien für die Krankenpflege ein und bringen Sie Ihre Karriere auf die nächste Stufe mit einer Weiterbildung, die Sie von anderen abhebt und Sie darauf vorbereitet, die Herausforderungen der Zukunft im Gesundheitswesen zu meistern.